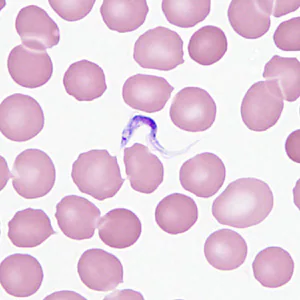
December - 2013 - Case #362

2013 DPDx Case Studies
DPDx Case Studies – 2013
December 2013
November 2013
October 2013
September 2013
August 2013
July 2013
June 2013
May 2013
April 2013
March 2013

A 26-year-old female presented at a local hospital with severe pain and bloody discharge from the ear. The symptoms started while on a returning flight from vacation in Central America. The patient explained that while on vacation she visited a local physician to have a fly removed from her ear canal.
February 2013
January 2013
DPDx is an educational resource designed for health professionals and laboratory scientists. For an overview including prevention, control, and treatment visit www.cdc.gov/parasites/.